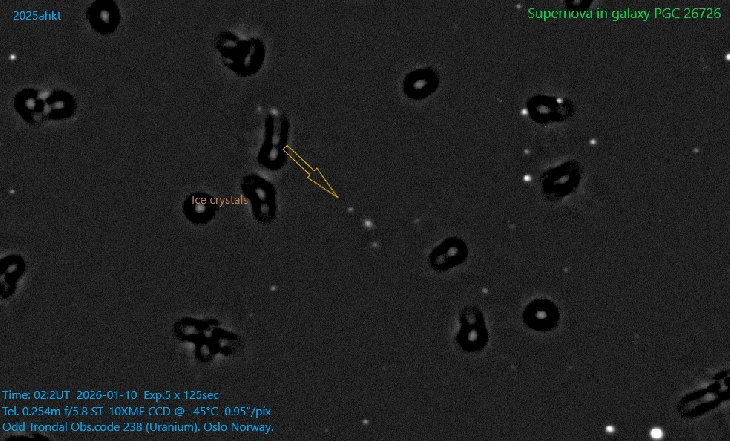

| More images
Details:
Time: 02:20UT 2026-01-10 Exp.5 x 125sec
Tel. 0.254m f/5.8 ST-10XME CCD @ -45°C 0.95"/pix
Odd Trondal Obs.code 238 (Uranium). Oslo Norway.
2025ahkt (= ZTF25acitiuq) discovered 2025/12/16.434 at R.A. = 09h25m42s.448,
Decl. = +22°20'05".72 Mag 16.2:12/29, Type Ia-91T (z=0.026) (zhost=0.026265)
(host CGCG 121-087)(References: TNS, ZTF observations)
Reference David Bishop http://www.rochesterastronomy.org/snimages/
Discovery page (References: TNS):
https://www.wis-tns.org/object/2025ahkt
Reference image from Aladin or Sloan Digital Sky Survey
Software used:TheSky6,CCDSoft 5, MSB Astroart 2.0, 8.0, Paint
Photographer's website:
https://www.flickr.com/photos/odd_trondal/
|